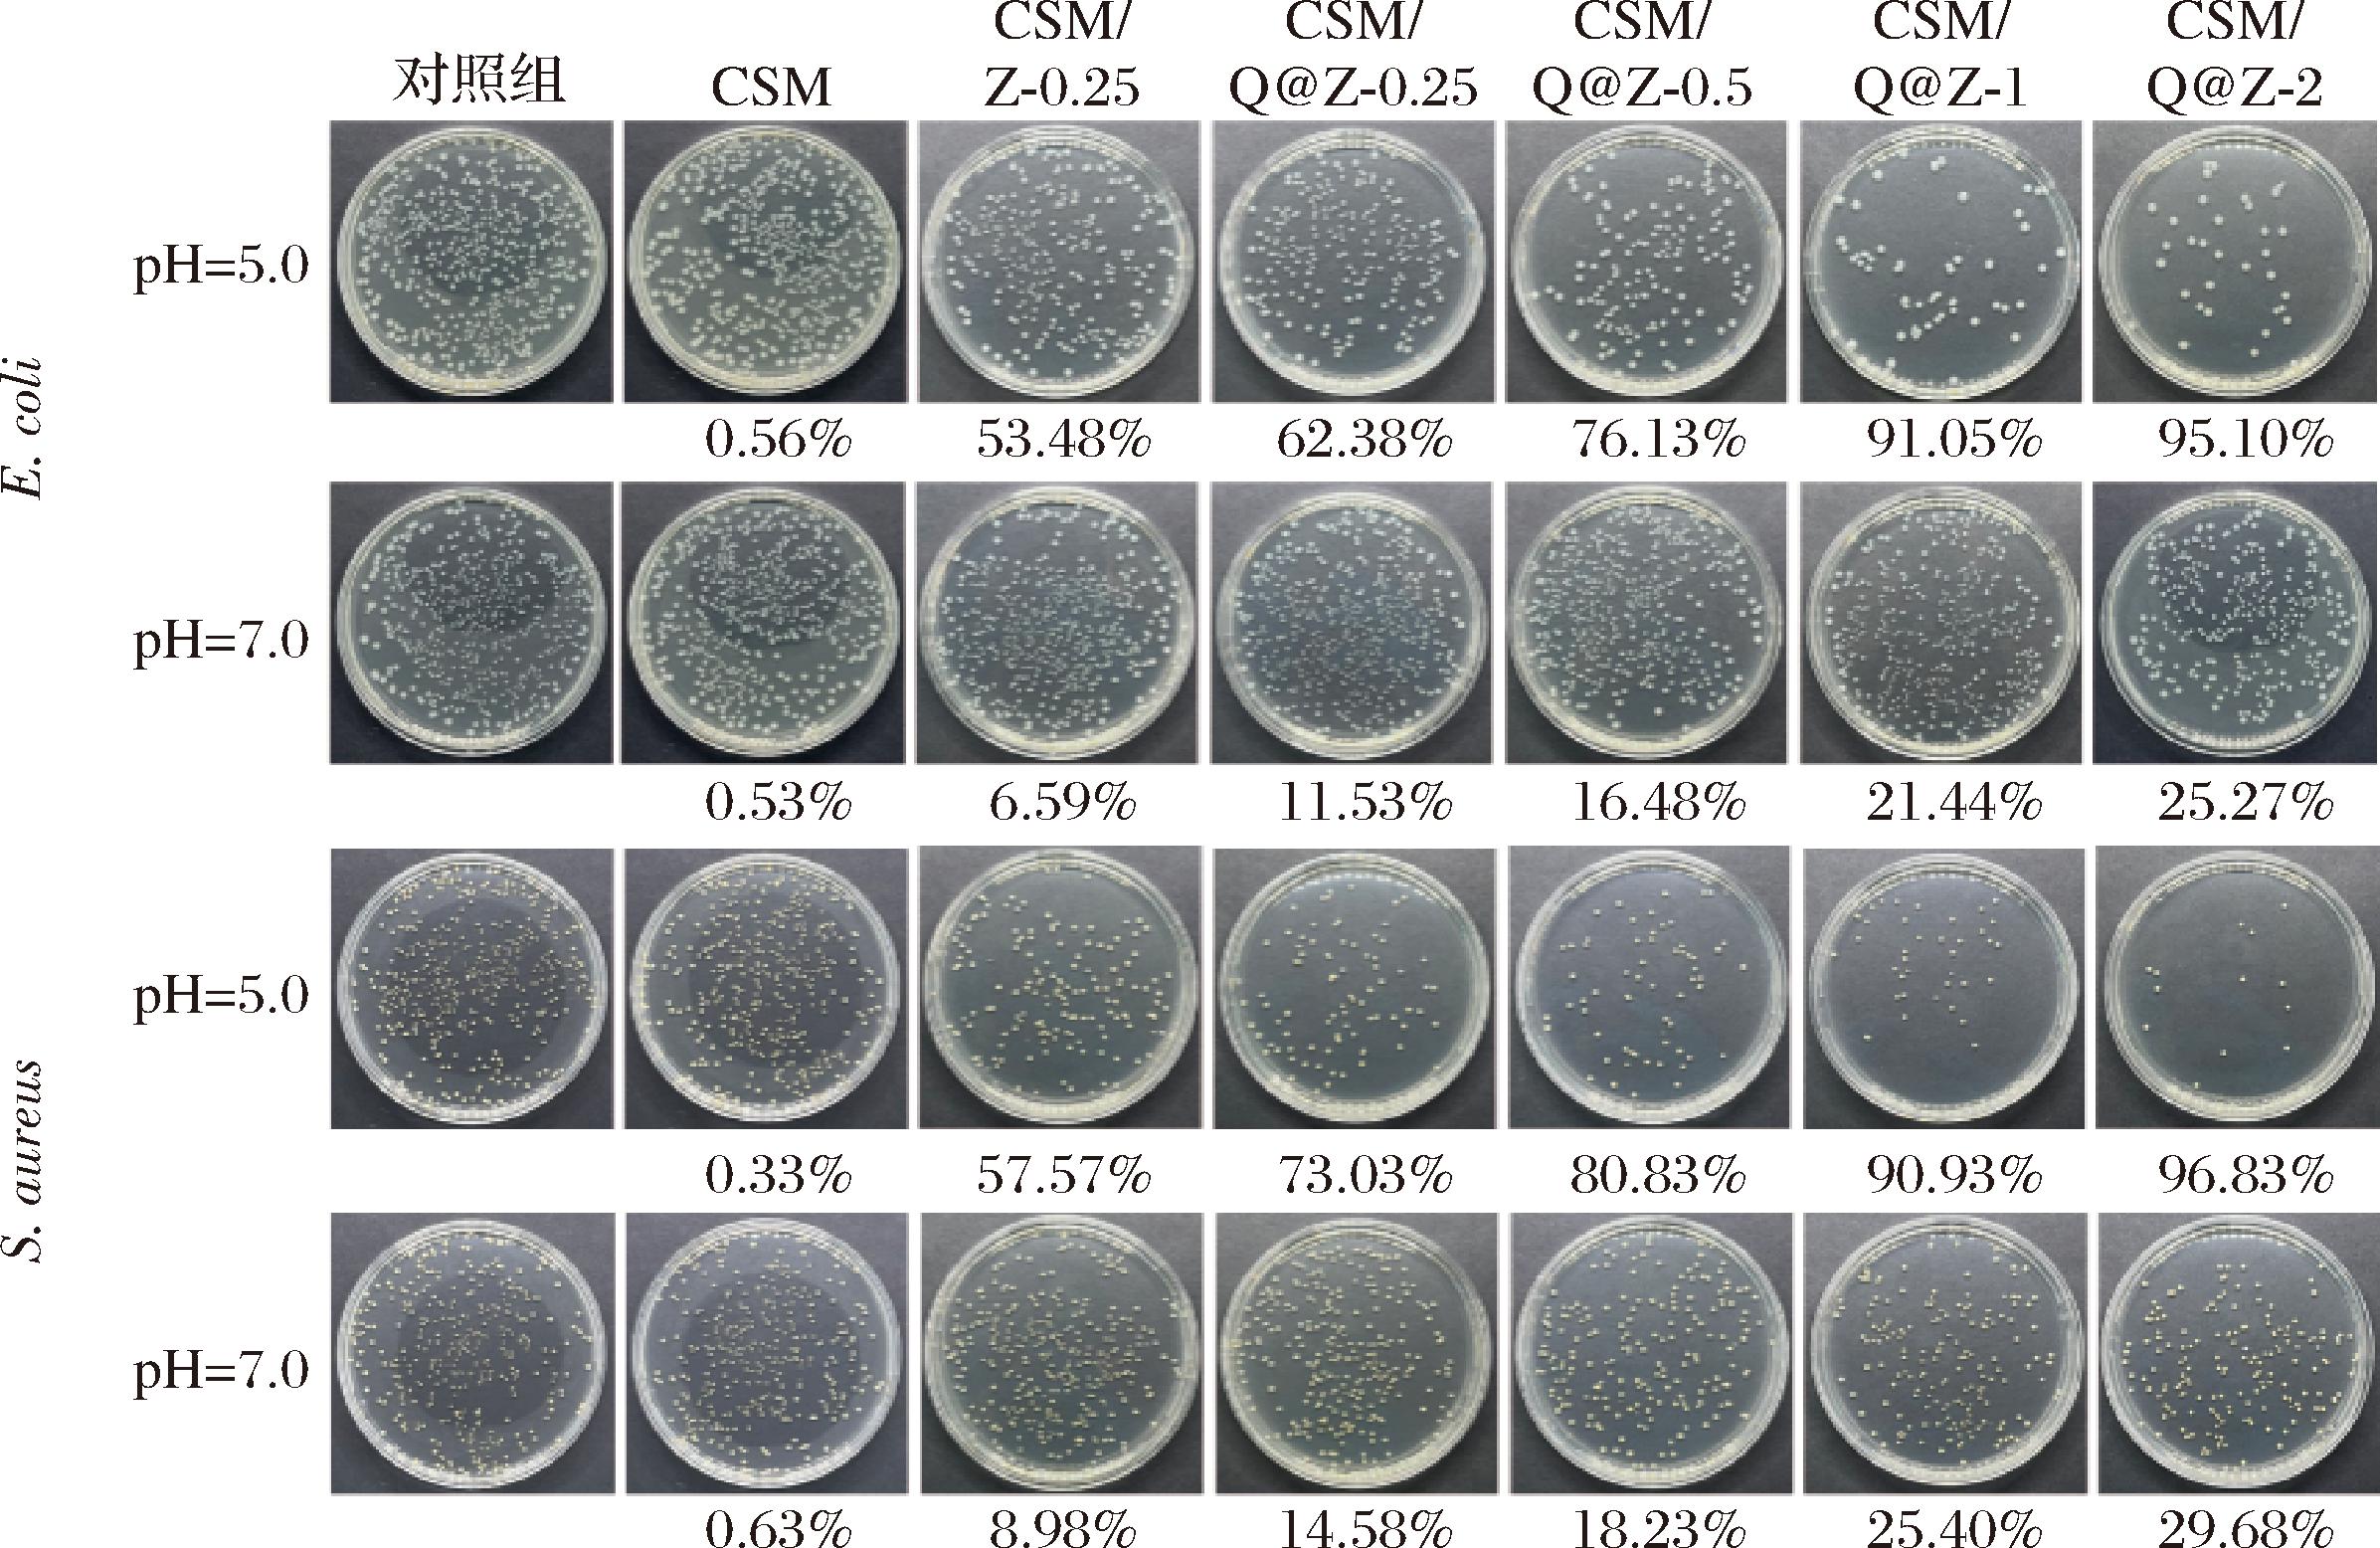

猪肉作为最主要的动物蛋白来源之一,其保鲜技术的研究备受关注。新鲜猪肉在贮藏过程中易发生微生物污染、脂肪氧化及水分流失,导致品质下降和货架期缩短[1]。多糖基气凝胶凭借可降解性、三维多孔性及吸水性,可作为猪肉保鲜的吸水衬垫。但抗菌抗氧化性能不足,遇水易溶胀破裂的问题使其应用受到限制[2]。通过适当交联及负载天然活性成分,可提升其综合性能,为肉类保鲜提供高效绿色解决方案[3-4]。WANG等[5]制备的负载柠檬醛的纤维素/海藻酸钠(sodium alginate,SA)气凝胶衬垫,对大肠杆菌和金黄色葡萄球菌表现出优异的抗菌性能,能将常温贮藏猪肉的保质期延长2 d。槲皮素(quercetin,Qu)作为一种天然黄酮类化合物,具有抗氧化与广谱抑菌活性[6-7]。ZHU等[8]将槲皮素掺入到聚乳酸基薄膜中,有效抑制了猪肉的氧化和变色,将冷鲜猪肉货架期延长2~4 d。槲皮素水溶性差、易降解的特性限制了其实际应用[9]。金属有机骨架材料ZIF-8凭借其高比表面积、pH响应释放能力、抗菌金属离子释放及良好的生物安全性,在活性分子负载与释放方面表现突出[10-11]。
为获得具有长期高效抗菌和抗氧化的新型复合气凝胶,本研究使用ZIF-8封装槲皮素,以获得具有pH响应释放性能的Qu@ZIF-8纳米粒子,以纤维素和海藻酸钠为基体,甲基三甲氧基硅烷(methyltrimethoxysilane,MTMS)为交联剂,采用冷冻干燥法制得气凝胶(命名为CSM),并探究不同的Qu@ZIF-8添加量对气凝胶孔隙结构、吸水能力、机械性能和抗菌抗氧化活性的影响。将复合气凝胶用作冷鲜猪肉的保鲜衬垫,定期测定贮藏期间冷鲜猪肉的汁液损失率、pH、菌落总数、挥发性盐基氮(total volatile basic nitrogen,TVB-N)和颜色变化,结合感官评价评估气凝胶衬垫对冷鲜猪肉的保鲜效果,以期拓展金属有机骨架材料在食品领域的应用场景,也为天然活性成分的高效利用及功能性气凝胶的设计提供新思路。
1 材料与方法
1.1 材料与试剂
Zn(NO3)2·H2O、2-甲基咪唑、槲皮素、MTMS、DPPH,上海麦克林生化科技有限公司;纳米纤维素纤丝(cellulose nanofibrils,CNF),天津木精灵生物科技有限公司;海藻酸钠、平板计数琼脂、无水乙醇、甲醇、氯化钠、氯化钾、氯化镁、硼酸、三氯乙酸、甲基红、亚甲基蓝,国药集团化学试剂有限公司;大肠杆菌和金黄色葡萄球菌,北京保藏生物科技有限公司;猪里脊肉,无锡市方庙市场。
1.2 仪器与设备
DZG-6020真空干燥箱,上海森信实验仪器有限公司;Velocity 18R台式冷冻离心机,天美仪拓实验室设备(上海)有限公司;Scientz-20F冷冻干燥机,宁波新芝生物科技股份有限公司;Evo18扫描电子显微镜,德国卡尔蔡司公司;JEOL JEM-2100F透射电子显微镜,日本电子株式会社;D2 PHASER A26-X1-A2E0B2A0 X射线衍射仪,德国布鲁克科技有限公司;Nicolet iS10傅里叶红外光谱仪,美国赛默飞世尔科技(中国)有限公司;E43-104万能试验机,美特斯工业系统(中国)有限公司;CR-400色差仪,柯尼卡美能达控股株式会社。
1.3 实验方法
1.3.1 ZIF-8和Qu@ZIF-8的制备
将150 mg Zn(NO3)2·H2O溶解于5 mL甲醇,330 mg 2-甲基咪唑和7 mg槲皮素溶解于10 mL甲醇。将2种溶液混合,以300 r/min的转速搅拌15 min,溶液由澄清透明逐渐变为乳黄色。将溶液在10 000 r/min下离心10 min,收集黄色沉淀,使用甲醇洗涤3次除去未反应的前体和游离的槲皮素。得到的沉淀在室温下真空干燥12 h获得封装槲皮素的ZIF-8(Qu@ZIF-8)。按照相同的方案制备ZIF-8,过程中不添加槲皮素。
1.3.2 气凝胶的制备
将CNF悬浮液均匀分散于去离子水中。称取1 g海藻酸钠溶解在49 mL去离子水中,在60 ℃下搅拌1 h。用HCl将水的pH调至4,以质量比1∶1将水和MTMS混合,以500 r/min的转速搅拌10 min制备聚硅氧烷溶胶。将1 mL聚硅氧烷溶胶加入到CNF溶液中,在室温下搅拌1 h后加入海藻酸钠溶液,继续搅拌2 h得到混合均匀的悬浮液。整个溶液体系中CNF和SA的含量为1.25%(质量分数,CNF与SA质量比为7∶3),聚硅氧烷溶胶为2.5%(质量分数)。将CNF/SA/MTMS悬浮液倒入模具中,-20 ℃预冻12 h,-60 ℃下冷冻干燥48 h。将得到的气凝胶60 ℃固化2 h,促进与硅烷的交联。得到的气凝胶命名为CSM。以等量的去离子水代替聚硅氧烷溶胶,制备未交联的CNF/SA气凝胶(CS)。按照同样的制备方案,向CNF/SA/MTMS悬浮液中分别加入质量分数为0.25%、0.5%、1%、2%的Qu@ZIF-8。得到的气凝胶命名为CSM/Q@Z-0.25,CSM/Q@Z-0.5,CSM/Q@Z-1和CSM/Q@Z-2,同时还制备了含0.25%ZIF-8的CSM/Z-0.25。
1.3.3 材料的表征与性能测试
1.3.3.1 透射电镜和扫描电镜分析
使用透射电镜观察ZIF-8和Qu@ZIF-8的微观结构,使用扫描电镜观察气凝胶的微观形貌。
1.3.3.2 X射线衍射(X-ray diffraction,XRD)分析
分析ZIF-8和Qu@ZIF-8的晶体结构,测量范围为5°~50°,步长0.02°。
1.3.3.3 傅里叶红外光谱(Fourier transform infrared spectroscopy,FT-IR)分析
在4 000~500 cm-1波数内扫描气凝胶的红外光谱。
1.3.3.4 气凝胶的性能测试
a)密度
测量气凝胶的直径、高度和质量。气凝胶的密度按公式(1)计算:
密度![]()
(1)
式中:m是气凝胶的质量,mg;V是气凝胶的体积,cm3。
b)孔隙率
使用乙醇置换法测量气凝胶的孔隙率[12]。将气凝胶浸泡无水乙醇24 h后称量。气凝胶的孔隙率按公式(2)计算:
孔隙率![]()
(2)
式中:M1是气凝胶浸泡乙醇后的质量,mg;M0是气凝胶的初始质量,mg;ρ是无水乙醇的密度,0.79 g/cm3;V是气凝胶的体积,cm3。
c)吸水能力
参考ZHANG等[13]的方法并做修改。将气凝胶浸泡在20 mL水中24 h,取出擦去表面的水分后称量。气凝胶的吸水能力(吸水倍率)按公式(3)计算:
吸水倍率![]()
(3)
式中:W1是气凝胶浸水后的质量,mg;W0是气凝胶的初始质量,mg。
d)抗压性能
使用直径为25 mm,高度为10 mm的圆柱形气凝胶试样。万能试验机的参数为:压缩速度12 mm/min,应变80%,记录材料的应力-应变曲线,取峰值应力表征抗压强度。
e)抗菌性能
参考MENG等[14]的菌落计数法测定。将9 mL pH 5.0和pH 7.0的无菌PBS分别与1 mL 107 CFU/mL的大肠杆菌和金黄色葡萄球菌菌悬液混合,加入100 mg 气凝胶,在37 ℃,175 r/min下振荡4 h,梯度稀释后涂布平板,37 ℃培养24 h后进行菌落计数。气凝胶的抑菌率按公式(4)计算:
抑菌率![]()
(4)
式中:C0是不含气凝胶的对应pH的缓冲液的菌落数,CFU;Cn是气凝胶组的菌落数,CFU。
f)抗氧化活性
参考NING等[15]的方法并做修改。将100 mg气凝胶浸入10 mL无水乙醇24 h,取1 mL上清液,与1 mL 0.1 mmol/L的DPPH乙醇溶液混合,避光反应1 h,测定517 nm处的吸光度。以等体积无水乙醇代替上清液作为空白对照。气凝胶的DPPH自由基清除率按公式(5)计算:
DPPH自由基清除率![]()
(5)
式中:A0是对照组的吸光度;An是气凝胶组的吸光度。
1.3.4 复合气凝胶对冷鲜猪肉的保鲜效果
将猪肉切成外观和质地均匀的尺寸约为6 cm×5 cm×2 cm的方块,每块约30 g,放入托盘包装盒中。对照组托盘底部无气凝胶,实验组分别使用CSM,含1% ZIF-8的CSM(CSM/ZIF-8),含1% Qu@ZIF-8的CSM(CSM/Qu@ZIF-8)。将所有猪肉样品在4 ℃冰箱中贮藏12 d,每2 d测定一次猪肉的各项指标。
猪肉在贮藏期间的汁液损失率按公式(6)计算:
汁液损失率![]()
(6)
式中:m0是猪肉第0天的质量;mn是第n天猪肉的质量。
猪肉的pH值测定参考GB 5009.237—2016《食品安全国家标准 食品pH值的测定》;菌落总数测定参考GB 4789.2—2022《食品安全国家标准 食品微生物学检验 菌落总数测定》;TVB-N含量测定参考GB 5009.228—2016《食品安全国家标准 食品中挥发性盐基氮的测定》;使用色差仪测定猪肉的亮度值(L*)和红度值(a*);感官评价参考GB 2707—2016《食品安全国家标准 鲜(冻)畜、禽产品》进行,由5名经过感官评价训练的人员按照表1所示的标准进行评分。
表1 猪肉感官评价表
Table 1 Sensory evaluation of pork

分值/分色泽气味弹性黏度 9~10色泽明亮,呈鲜红色鲜味足回弹性好表面微湿,不黏手6~8色泽稍有暗淡,颜色变浅鲜味淡,但无异味按压后稍有凹陷稍微黏手4~5颜色发白有轻微异味按压后回弹不明显,凹陷较深较黏手1~3色泽暗淡,出现红褐色腐臭味明显,有发酸发酵异味无弹性,按压后不恢复十分黏手
1.4 数据统计与分析
所有实验均进行3次,结果表示为“平均值±标准差”。使用SPSS 22统计分析软件进行方差分析,采用Duncan多重比较法进行显著性分析,P<0.05表示差异显著。使用Origin 2022软件绘图。
2 结果与分析
2.1 ZIF-8和Qu@ZIF-8的表征
2.1.1 微观形貌
如图1所示,ZIF-8和Qu@ZIF-8均呈现正十二面体的结构。封装槲皮素使ZIF-8的颜色从白色变为黄色,粒径变大,但ZIF-8的结构完整性没有被破坏,这对保持ZIF-8的功能完整尤为重要。

a-ZIF-8;b-Qu@ZIF-8
图1 ZIF-8和Qu@ZIF-8的微观形貌
Fig.1 Microstructure of ZIF-8 and Qu@ZIF-8
2.1.2 XRD
如图2所示,ZIF-8在7.46°、10.36°、12.60°、17.95°处的特征衍射峰分别对应(011)、(002)、(112)和(222)晶面,与LI等[16]的报道的ZIF-8衍射特征一致。在Qu@ZIF-8的XRD谱中能观察到所有ZIF-8的特征峰,证明槲皮素不会影响ZIF-8的晶体结构,但未观察到槲皮素的特征峰,这是由于槲皮素被封装在ZIF-8的孔道内部中,而不是简单地吸附在ZIF-8表面[17]。

图2 槲皮素、ZIF-8和Qu@ZIF-8的XRD谱图
Fig.2 XRD patterns of Quercetin, ZIF-8, and Qu@ZIF-8
2.2 气凝胶的性能分析
2.2.1 物理性质及力学性能
如表2所示,交联前后的气凝胶均表现出低密度、高孔隙率的特点,高孔隙率有利于抗菌物质的固定和释放。未交联的CS在水中会发生溶胀变形和溶解,而CSM展现出良好的水稳定性和较强吸水能力。随着Qu@ZIF-8添加量的增加,气凝胶的孔隙率和吸水能力下降,这是因为Qu@ZIF-8可能会堵塞孔道,从而阻碍水分在毛细作用下的传输路径,此外,Qu@ZIF-8的疏水表面可能限制水分在气凝胶内部的渗透,从而影响材料的吸水能力。HATAMI等[18]使用CaCl2交联纤维素和海藻酸钠制备的气凝胶,其吸水倍率约为14,而本研究制备的CSM气凝胶吸水倍率为23.94,最高Qu@ZIF-8添加量的气凝胶吸水倍率仍可达15.93,展现出较优的吸水能力。
表2 气凝胶的密度、孔隙率、吸水倍率和抗压强度
Table 2 The density, porosity, water absorption ratio, and compressive strength of aerogel

组别密度/(mg/cm3)孔隙率/%吸水倍率抗压强度/kPaCS20.52±0.55f91.67±0.58a—154.04±3.52fCSM21.91±0.64e89.34±0.72b23.94±0.62a220.16±3.66bCSM/Q@Z-0.2523.88±0.53d86.49±1.31c23.36±0.75a188.07±5.15eCSM/Q@Z-0.525.35±0.77c83.99±0.93d23.08±0.85a201.34±3.13dCSM/Q@Z-129.70±0.46b80.00±0.65e20.35±1.09b213.37±3.35cCSM/Q@Z-233.71±1.00a73.14±1.14f15.93±1.05c227.52±2.91a
注:同列不同小写字母表示组间差异显著(P<0.05);“—”表示无此项指标。
气凝胶的抗压能力对保持孔道结构,维持抗菌物质的释放不受影响具有重大意义。MTMS水解生成的硅醇(Si—OH)与CNF和SA的羟基或羧基缩合,形成Si—O—C共价键,并将Si—O—Si连接到CNF/SA链上,形成刚性网络,有效抵抗压缩应力[19]。低添加量的Qu@ZIF-8可能造成应力集中或界面结合不佳,导致抗压强度降低。随着Qu@ZIF-8含量增加,形成连续增强相,从而提高材料的抗压强度。
2.2.2 微观形貌
图3-a和图3-b为气凝胶截面的扫描电镜图像。CNF和SA之间以氢键和物理缠绕的弱相互作用力为主,呈现出松散的片状结构和不规则的孔道。当引入MTMS作为交联剂后,形成共价键增强分子间作用力,使气凝胶的孔道结构趋于规则化,呈现出有序的多孔网络,有利于提高材料的力学性能,这与气凝胶呈现的抗压强度结果相一致。由图3-c和图3-d可以观察到,Qu@ZIF-8均匀地吸附在气凝胶的孔壁上,在微观尺度上轻微影响孔道成型的均匀性,但未显著破坏气凝胶的共价交联框架。

a-CS;b-CSM;c-CSM/Q@Z-1;d-Qu@ZIF-8在CSM/Q@Z-1中的分布
图3 气凝胶的微观形貌
Fig.3 The microstructure of aerogels
2.2.3 FT-IR
如图4所示,添加了MTMS后,1 276 cm-1和782 cm-1处的吸收峰对应Si—C和Si—O—Si,表明硅氧烷网络的形成[20]。1 035 cm-1处的峰有所增强,对应Si—O—C键的不对称拉伸,表明共价键的形成[21]。此外,在CSM/Q@Z-1在760 cm-1和418 cm-1处出现了属于Qu@ZIF-8的特征峰,表明其在气凝胶中保持完整。

图4 气凝胶的FT-IR光谱图
Fig.4 FT-IR spectrogram of aerogel
2.2.4 抗菌性能
如图5所示,Qu@ZIF-8使气凝胶对大肠杆菌和金黄色葡萄球菌表现出良好的抑菌效果,当添加量超过1%,抑菌率可达到90%以上。气凝胶显示出酸响应型抗菌的特点,pH 5.0组的抑菌率均高于pH 7.0组。这是由于酸性环境下2-甲基咪唑配体质子化,Zn2+与咪唑环的配位键破裂,使ZIF-8分解释放出Zn2+和槲皮素协同抗菌[22]。
图5 气凝胶在不同pH下对大肠杆菌和金黄色葡萄球菌的抑菌效果
Fig.5 pH-dependent antibacterial activity of aerogels against E.coli and S.aureus
与大肠杆菌相比,气凝胶对金黄色葡萄球菌的抑制率更高,WANG等[17]研究报道了姜黄素@ZIF-8复合水凝胶类也有类似现象。这可归因于细菌的细胞结构不同,金黄色葡萄球菌的肽聚糖层更易被穿透。
2.2.5 抗氧化活性
DPPH自由基清除率可用来评估材料的抗氧化能力,清除率越高代表抗氧化能力越强,气凝胶的DPPH自由基清除率如图6所示。CSM、CSM/Z-0.25、CSM/Q@Z-0.25、CSM/Q@Z-0.5、CSM/Q@Z-1、CSM/Q@Z-2的DPPH自由基清除率分别是6.23%、13.83%、46.97%、65.89%、78.92%、82.79%。气凝胶的抗氧化活性随Qu@ZIF-8的加入显著增强(P<0.05)。CSM/Q@Z-0.25的DPPH自由基清除率较CSM/Z-0.25提高了30%以上,这是由于槲皮素的酚羟基具有优异的DPPH自由基清除能力[23]。在ZHANG等[24]的研究中,游离槲皮素的DPPH自由基清除率可达92.0%,使用载体包覆槲皮素后DPPH自由基清除率略有下降,但能有效地保护槲皮素的生物活性。

图6 气凝胶的自由基清除率
Fig.6 Free radical scavenging rate of aerogels
注:同列不同字母表示组间差异显著(P<0.05)。
2.3 复合气凝胶的猪肉保鲜应用
2.3.1 汁液损失率
在鲜肉贮藏期间,微生物繁殖造成组织细胞破坏,进而导致脂肪和蛋白质的氧化分解及水分流失。如图7所示,各组的汁液损失率都呈上升趋势。冷藏12 d后,CSM、CSM/ZIF-8、CSM/Qu@ZIF-8组的汁液损失率分别为9.35%、8.65%、8.27%,这是由于ZIF-8和Qu@ZIF-8赋予气凝胶抗菌和抗氧化能力,抑制微生物的生长和鲜肉氧化。此外,由于气凝胶的高吸水性,汁液损失率均显著高于对照组的3.94%(P<0.05)。JIANG等[25]使用吸水垫也出现了类似结果,并发现使用吸水衬垫后能将鲜肉的保鲜期延长至少3 d。这是因为鲜肉渗出的汁液为微生物生长提供有利条件,通过衬垫及时吸收托盘中的水分,有助于延缓鲜肉的变质。

图7 气凝胶衬垫对猪肉汁液损失率的影响
Fig.7 Effect of aerogel pads on juice loss rate in pork
注:同一贮藏时间下不同气凝胶衬垫的差异显著性以大写字母表示,同一气凝胶衬垫不同贮藏时间的差异显著性以小写字母表示,字母不同代表差异显著(P<0.05)(下同)。
2.3.2 pH
在微生物和酶的作用下,肉类的蛋白质会分解并产生氨、胺等碱性物质,因此,猪肉的pH会随着贮藏时间延长而逐渐升高。如图8所示,各组鲜肉的pH均呈现先降后升的趋势,初期pH降低可能与猪肉酶解产生的乳酸和肌肉三磷酸腺苷降解产生的磷酸有关[26]。猪肉的pH值超过6.7即为变质肉[5]。对照组的猪肉在第8天时pH值已达6.88,CSM和CSM/ZIF-8组在第10天时的pH值分别是6.92和6.75,而CSM/Qu@ZIF-8组在第12天时的pH值仅为6.6,表明使用CSM/Qu@ZIF-8气凝胶能有效减缓pH的上升,延长猪肉的保鲜期。

图8 气凝胶衬垫对猪肉pH的影响
Fig.8 Effect of aerogel pads on pH of pork
2.3.3 菌落总数
猪肉中的菌落总数是评价猪肉质量的重要指标,根据GB/T 9959.2—2008《分割鲜、冻猪瘦肉》,猪肉的菌落总数大于6 lg CFU/g时为变质肉。如图9所示,对照组在第6天时菌落总数已达6.17 lg CFU/g,CSM的菌落总数在第8天时为6.13 lg CFU/g,CSM/ZIF-8菌落总数在第10天时为6.14 lg CFU/g。而CSM/Qu@ZIF-8组在第12天时仅为6.01 lg CFU/g,略超过变质标准,这是由于Qu@ZIF-8受微酸性猪肉汁液触发,释放出Zn2+和槲皮素抑制微生物的生长。MALVANO等[27]开发了能延长鸡胸肉片保鲜期的槲皮素-海藻酸盐涂层,槲皮素通过增加细菌细胞膜通透性,并利用其酚类成分抑制钙、钾离子的跨膜运输,抑制肉类腐败菌的生长,使涂层处理组的菌落总数达到安全限值的时间较对照组延迟3 d。

图9 气凝胶衬垫对猪肉菌落总数的影响
Fig.9 Effect of aerogel pads on the total bacterial count in pork
2.3.4 TVB-N
TVB-N主要由蛋白质分解产生的胺、氨类化合物组成,是用来评价肉类新鲜度和蛋白质氧化程度的关键指标[28]。贮藏期间猪肉的TVB-N含量变化如图10所示,所有猪肉样品的TVB-N含量均呈现上升趋势。GB 2707—2016《食品安全国家标准 鲜(冻)畜、禽产品》规定,猪肉的TVB-N含量超过15 mg/100 g即为变质肉。在第6天时,对照组的TVB-N含量已超过限定值,达到15.60 mg/100 g,显著高于使用了衬垫的实验组(P<0.05),而CSM、CSM/ZIF-8和CSM/Qu@ZIF-8组的TVB-N含量分别在第8、10和12天超过了鲜肉标准,CSM/Qu@ZIF-8组的TVB-N含量较对照组减少了45.62%,这归因于气凝胶的抑制微生物生长和蛋白质氧化能力。GAO等[29]使用椰子外果类黄酮处理金鲳鱼,黄酮类化合物通过抑制三甲胺等生物胺的生成,使贮藏期内TVB-N含量减少近25%。

图10 气凝胶衬垫对猪肉TVB-N含量的影响
Fig.10 Effect of aerogel pads on TVB-N content in pork
2.3.5 色差分析
猪肉的颜色直接影响消费者对猪肉品质的判断,图11-a和图11-b中贮藏期间猪肉的包装L*和a*值分别反映了亮度和红度的变化。L*与a*值均呈现出下降趋势,这是由于猪肉中的肌红蛋白会逐渐氧化为棕褐色的高铁肌红蛋白,使猪肉颜色变暗且红度降低,此外,微生物生长和水分流失也导致肉色变暗。CSM/Qu@ZIF-8组在贮藏周期内表现出了较高的L*和a*值,这是由于气凝胶的抗菌和抗氧化能力,有效延缓了鲜肉的变色。XU等[30]发现黄酮类化合物能抑制脂质氧化和高铁肌红蛋白的生成,对维持肉类颜色有积极意义。

a-L*值;b-a*值
图11 气凝胶衬垫对猪肉亮度和红度的影响
Fig.11 Effect of aerogel pads on the lightness and redness of pork
2.3.6 感官评价
对贮藏期间的猪肉进行感官评价,其外观变化和感官评分分别如图12-a和图12-b所示。随着时间延长,猪肉由初始的鲜红色逐渐变暗淡和发白,最后出现明显的红褐色变质区域,这与L*与a*的测试结果一致。CSM/Qu@ZIF-8组猪肉的色泽、气味、弹性和黏度评价均高于其他组,对照组在第6天时按压后的恢复程度和速度降低并轻微黏手,在第12天时各组区别明显,对照组表面发干变硬情况严重,肌肉结构松散失去弹性,十分黏腻并伴随较大异味,而CSM/Qu@ZIF-8组出现了轻微的异味和黏手现象。微生物分解蛋白质和脂肪会导致肌肉结构松散,同时代谢产生多糖物质使表面发黏,此外,脂质氧化增加细胞膜通透性,导致胞质溶胶渗出会加重结构和触感的恶化[31]。

a-外观;b-感官评分
图12 贮藏期间猪肉的外观图片和感官评分
Fig.12 Appearance images and sensory evaluation of pork during storage
3 结论与讨论
本研究使用沸石咪唑类金属有机骨架ZIF-8封装槲皮素,制成了具有酸响应抗菌性能的Qu@ZIF-8纳米粒子。利用MTMS交联CNF和SA,添加质量分数1%的Qu@ZIF-8,得到了具有低密度(29.70 mg/cm3)、高孔隙率(80.00%)、超吸水能力(20.35倍)和优异抗压强度(213.37 kPa)的复合气凝胶CSM/Qu@ZIF-8。CSM/Qu@ZIF-8的DPPH自由基清除率达78.92%,并具有酸响应抗菌功能,在pH 5.0时对大肠杆菌和金黄色葡萄球菌的抑菌率分别为91.05%和90.93%(相比中性环境提高65%以上)。与不含气凝胶衬垫的对照组相比,CSM/Qu@ZIF-8气凝胶衬垫可快速吸收冷鲜猪肉贮藏过程中渗出的汁液,并受其触发释放锌离子和槲皮素,有效延缓冷鲜猪肉pH、菌落总数和TVB-N含量的升高,将冷鲜猪肉的保质期延长6 d。在食品贮藏过程中,微生物的生长代谢产生微酸性环境,CSM/Qu@ZIF-8气凝胶有望成为具有高效持久抗菌抗氧化效果的包装材料。
[1] 孙彦梅, 田铸, 李雪茹, 等.冰温保鲜技术对肉品的调控及其应用研究进展[J].食品工业, 2024, 45(6):233-237.SUN Y M, TIAN Z, LI X R, et al.Research progress on regulation and application of ice temperature preservation technology to meat[J].The Food Industry, 2024, 45(6):233-237.
[2] 王雪, 朱昆萌, 彭长鑫, 等.生物可降解多糖气凝胶材料的研究进展[J].材料导报, 2019, 33(z1):476-480.WANG X, ZHU K M, PENG C X, et al.Research progress of biodegradable polysaccharides aerogels[J].Materials Reports, 2019, 33(S1):476-480.
[3] 张春燕, 卢立新, 潘嘹.基于香芹酚和亚硝酸钠释放的聚对苯二甲酸乙二醇酯/低密度聚乙烯活性包装膜对猪肉护色保质作用研究[J].食品与发酵工业, 2025, 51(2):8-15.ZHANG C Y, LU L X, PAN L.Effect of polyethylene terephthalate/low-density polyethylene active packaging film based on release of carvacrol and sodium nitrite on color and quality preservation of pork[J].Food and Fermentation Industries, 2025, 51(2):8-15.
[4] 余冬青, 赵欣欣, 程赤云, 等.迭香精油活性贴对鲜切猪肉保鲜效果的研究[J].包装工程, 2023, 44(11):46-54.YU D Q, ZHAO X X, CHENG C Y, et al.Preservation effect of rosemary essential oil active packaging on fresh-cut pork[J].Packaging Engineering, 2023, 44(11):46-54.
[5] WANG S Y, WANG F J, LU C H, et al.Citral-loaded nanocellulose/sodium alginate aerogel packaging liner for fresh pork preservation[J].Food Control, 2024, 155:110031.
[6] 赵钜阳, 袁惠萍, 孙昕萌, 等.槲皮素对大马哈鱼复合香肠贮藏品质的影响[J].中国调味品, 2022, 47(10):52-56.ZHAO J Y, YUAN H P, SUN X M, et al.Effect of quercetin on storage quality of salmon compound sausage[J].China Condiment, 2022, 47(10):52-56.
[7] 林晓霞, 朱莉, 马静怡, 等.槲皮素杜仲多糖纳米颗粒的表征、抗氧化及抗炎活性[J].食品工业科技, 2025,46(15):126-134.LIN X X, ZHU L, MA J Y, et al.Characterization, antioxidant and anti-inflammatory activities of quercetin-Eucommia ulmoides polysaccharide nanoparticles[J].Science and Technology of Food Industry, 2025,46(15):126-134.
[8] ZHU C Q, YANG Q F, TIAN M, et al.Sustainable nanofiber films based on polylactic acid/modified cellulose nanocrystals containing various types of polyphenols, exhibiting antioxidant activity and high stability[J].Food Chemistry, 2025, 477:143514.
[9] KANG M J, KIM D Y, BAEK Y J, et al.Enhancement of antioxidant activities and stabilities of quercetin and isoquercetin through the combination of nanoencapsulation and hydrogel incorporation[J].Food Bioscience, 2023, 55:102963.
[10] 安重鑫, 马建中, 张雷.聚合物基MOFs复合材料抗菌研究进展[J].精细化工, 2024, 41(10):2120-2130.AN C X, MA J Z, ZHANG L.Progress in antibacterial research of polymer-based MOFs composites[J].Fine Chemicals, 2024, 41(10):2120-2130.
[11] 李京燕, 熊楠, 樊一凡, 等.Cu-ZIF-8金属有机框架纳米材料的合成及抗菌性能研究[J/OL].厦门大学学报(自然科学版):2024.https://kns.cnki.net/kcms/detail/35.1070.N.20240828.1701.010.html.LI J Y, XIONG N, FAN Y F, et al.Synthesis and antibacterial properties of Cu-ZIF-8 metal organic framework nanomaterials[J/OL].Journal of Xiamen University (Natural Science), 2024.https://kns.cnki.net/kcms/detail/35.1070.N.20240828.1701.010.html.
[12] YUE X P, DENG W H, ZHOU Z G, et al.Reinforced and flame retarded cellulose nanofibril/sodium alginate compound aerogel fabricated via boric acid/Ca2+ double cross-linking[J].Journal of Polymers and the Environment, 2023, 31(3):1038-1050.
[13] ZHANG K, LI Z H, KHAN S, et al.An intelligent aerogel composed of anthocyanins, natural fiber, carboxymethyl cellulose, and sodium alginate for monitoring fish freshness[J].International Journal of Biological Macromolecules, 2025, 297:138198.
[14] MENG Q, XUE Z, CHEN S L, et al.Smart antimicrobial Pickering emulsion stabilized by pH-responsive cellulose-based nanoparticles[J].International Journal of Biological Macromolecules, 2023, 233:123516.
[15] NING H Y, LU L X, XU J, et al.Development of sodium alginate-based antioxidant and antibacterial bioactive films added with IRMOF-3/Carvacrol[J].Carbohydrate Polymers, 2022, 292:119682.
[16] LI Y S, SHAN P, YU F Y, et al.Fabrication and characterization of waste fish scale-derived gelatin/sodium alginate/carvacrol loaded ZIF-8 nanoparticles composite films with sustained antibacterial activity for active food packaging[J].International Journal of Biological Macromolecules, 2023, 230:123192.
[17] WANG S Y, MA Y, WANG F J, et al.Development of cellulose-based self-healing hydrogel smart packaging for fish preservation and freshness indication[J].Carbohydrate Polymers, 2025, 348(Part A):122806.
[18] HATAMI T, CIDREIRA A C M, LINAN L Z, et al.Valorization of acai bagasse into cellulose nanofibers/sodium alginate aerogels[J].Waste and Biomass Valorization, 2024, 15(4):2451-2467.
[19] ZHANG X X, WANG H K, CAI Z Y, et al.Highly compressible and hydrophobic anisotropic aerogels for selective oil/organic solvent absorption[J].ACS Sustainable Chemistry &Engineering, 2019, 7(1):332-340.
[20] QIN H F, ZHANG Y F, JIANG J G, et al.Multifunctional superelastic cellulose nanofibrils aerogel by dual ice-templating assembly[J].Advanced Functional Materials, 2021, 31(46):2106269.
[21] MENG C H, ZHANG H, ZHANG S, et al.The preparation of hydrophobic alginate-based fibrous aerogel and its oil absorption property[J].Journal of Sol-Gel Science and Technology, 2018, 87(3):704-712.
[22] CAI W L, ZHANG W, CHEN Z L.Magnetic Fe3O4@ZIF-8 nanoparticles as a drug release vehicle:pH-Sensitive release of norfloxacin and its antibacterial activity[J].Colloids and Surfaces B:Biointerfaces, 2023, 223:113170.
[23] 武琼琼, 梁雯菁, 李少康, 等.槲皮素-山奈酚共递送体系的构建及表征[J].粮食与油脂, 2024, 37(10):113-118.WU Q Q, LIANG W J, LI S K, et al.Construction and characterization of quercetin-kaempferol co-delivery system[J].Cereals &Oils, 2024, 37(10):113-118.
[24] ZHANG Z H, HU Y, JI H Y, et al.Physicochemical stability, antioxidant activity, and antimicrobial activity of quercetin-loaded zein nanoparticles coated with dextrin-modified anionic polysaccharides[J].Food Chemistry, 2023, 415:135736.
[25] JIANG C G, YU G R, WANG P D, et al.Preparation of delignified wood fibers based absorbent pad for tray package and its application in preservation of cold and fresh pork[J].Industrial Crops and Products, 2024, 219:119097.
[26] ZHANG N, XU X K, ZHANG S M, et al.Graphene oxide enhanced nanocellulose/chitosan biodegradable aerogel pad for fresh pork preservation[J].Food and Bioprocess Technology, 2024, 17(12):4768-4780.
[27] MALVANO F, MONTONE A M I, CAPUANO F, et al.Effects of active alginate edible coating enriched with hydroxyapatite-quercetin complexes during the cold storage of fresh chicken fillets[J].Food Packaging and Shelf Life, 2022, 32:100847.
[28] DENG N, HU Z Q, LI H, et al.Physicochemical properties and pork preservation effects of lotus seed drill core powder starch-based active packaging films[J].International Journal of Biological Macromolecules, 2024, 260(Part 1):129340.
[29] GAO C Y, ZHAO M T, WANG X W, et al.Plasma-activated water in combination with coconut exocarp flavonoids emerge as promising preservation technique for golden pompano:Impact of the treatment sequence[J].Food Chemistry, 2024, 447:138981.
[30] XU F, WANG C X, WANG H F, et al.Antimicrobial action of flavonoids from Sedum aizoon L.against lactic acid bacteria in vitro and in refrigerated fresh pork meat[J].Journal of Functional Foods, 2018, 40:744-750.
[31] BERNARDI D M, BERTOL T M, COLDEBELLA A, et al.Effects of dietary flaxseed oil with or without products with antioxidant properties on pig performance, carcass characteristics, meat quality and oxidative stability[J].Animal Production Science, 2022, 62(18):1789-1804.